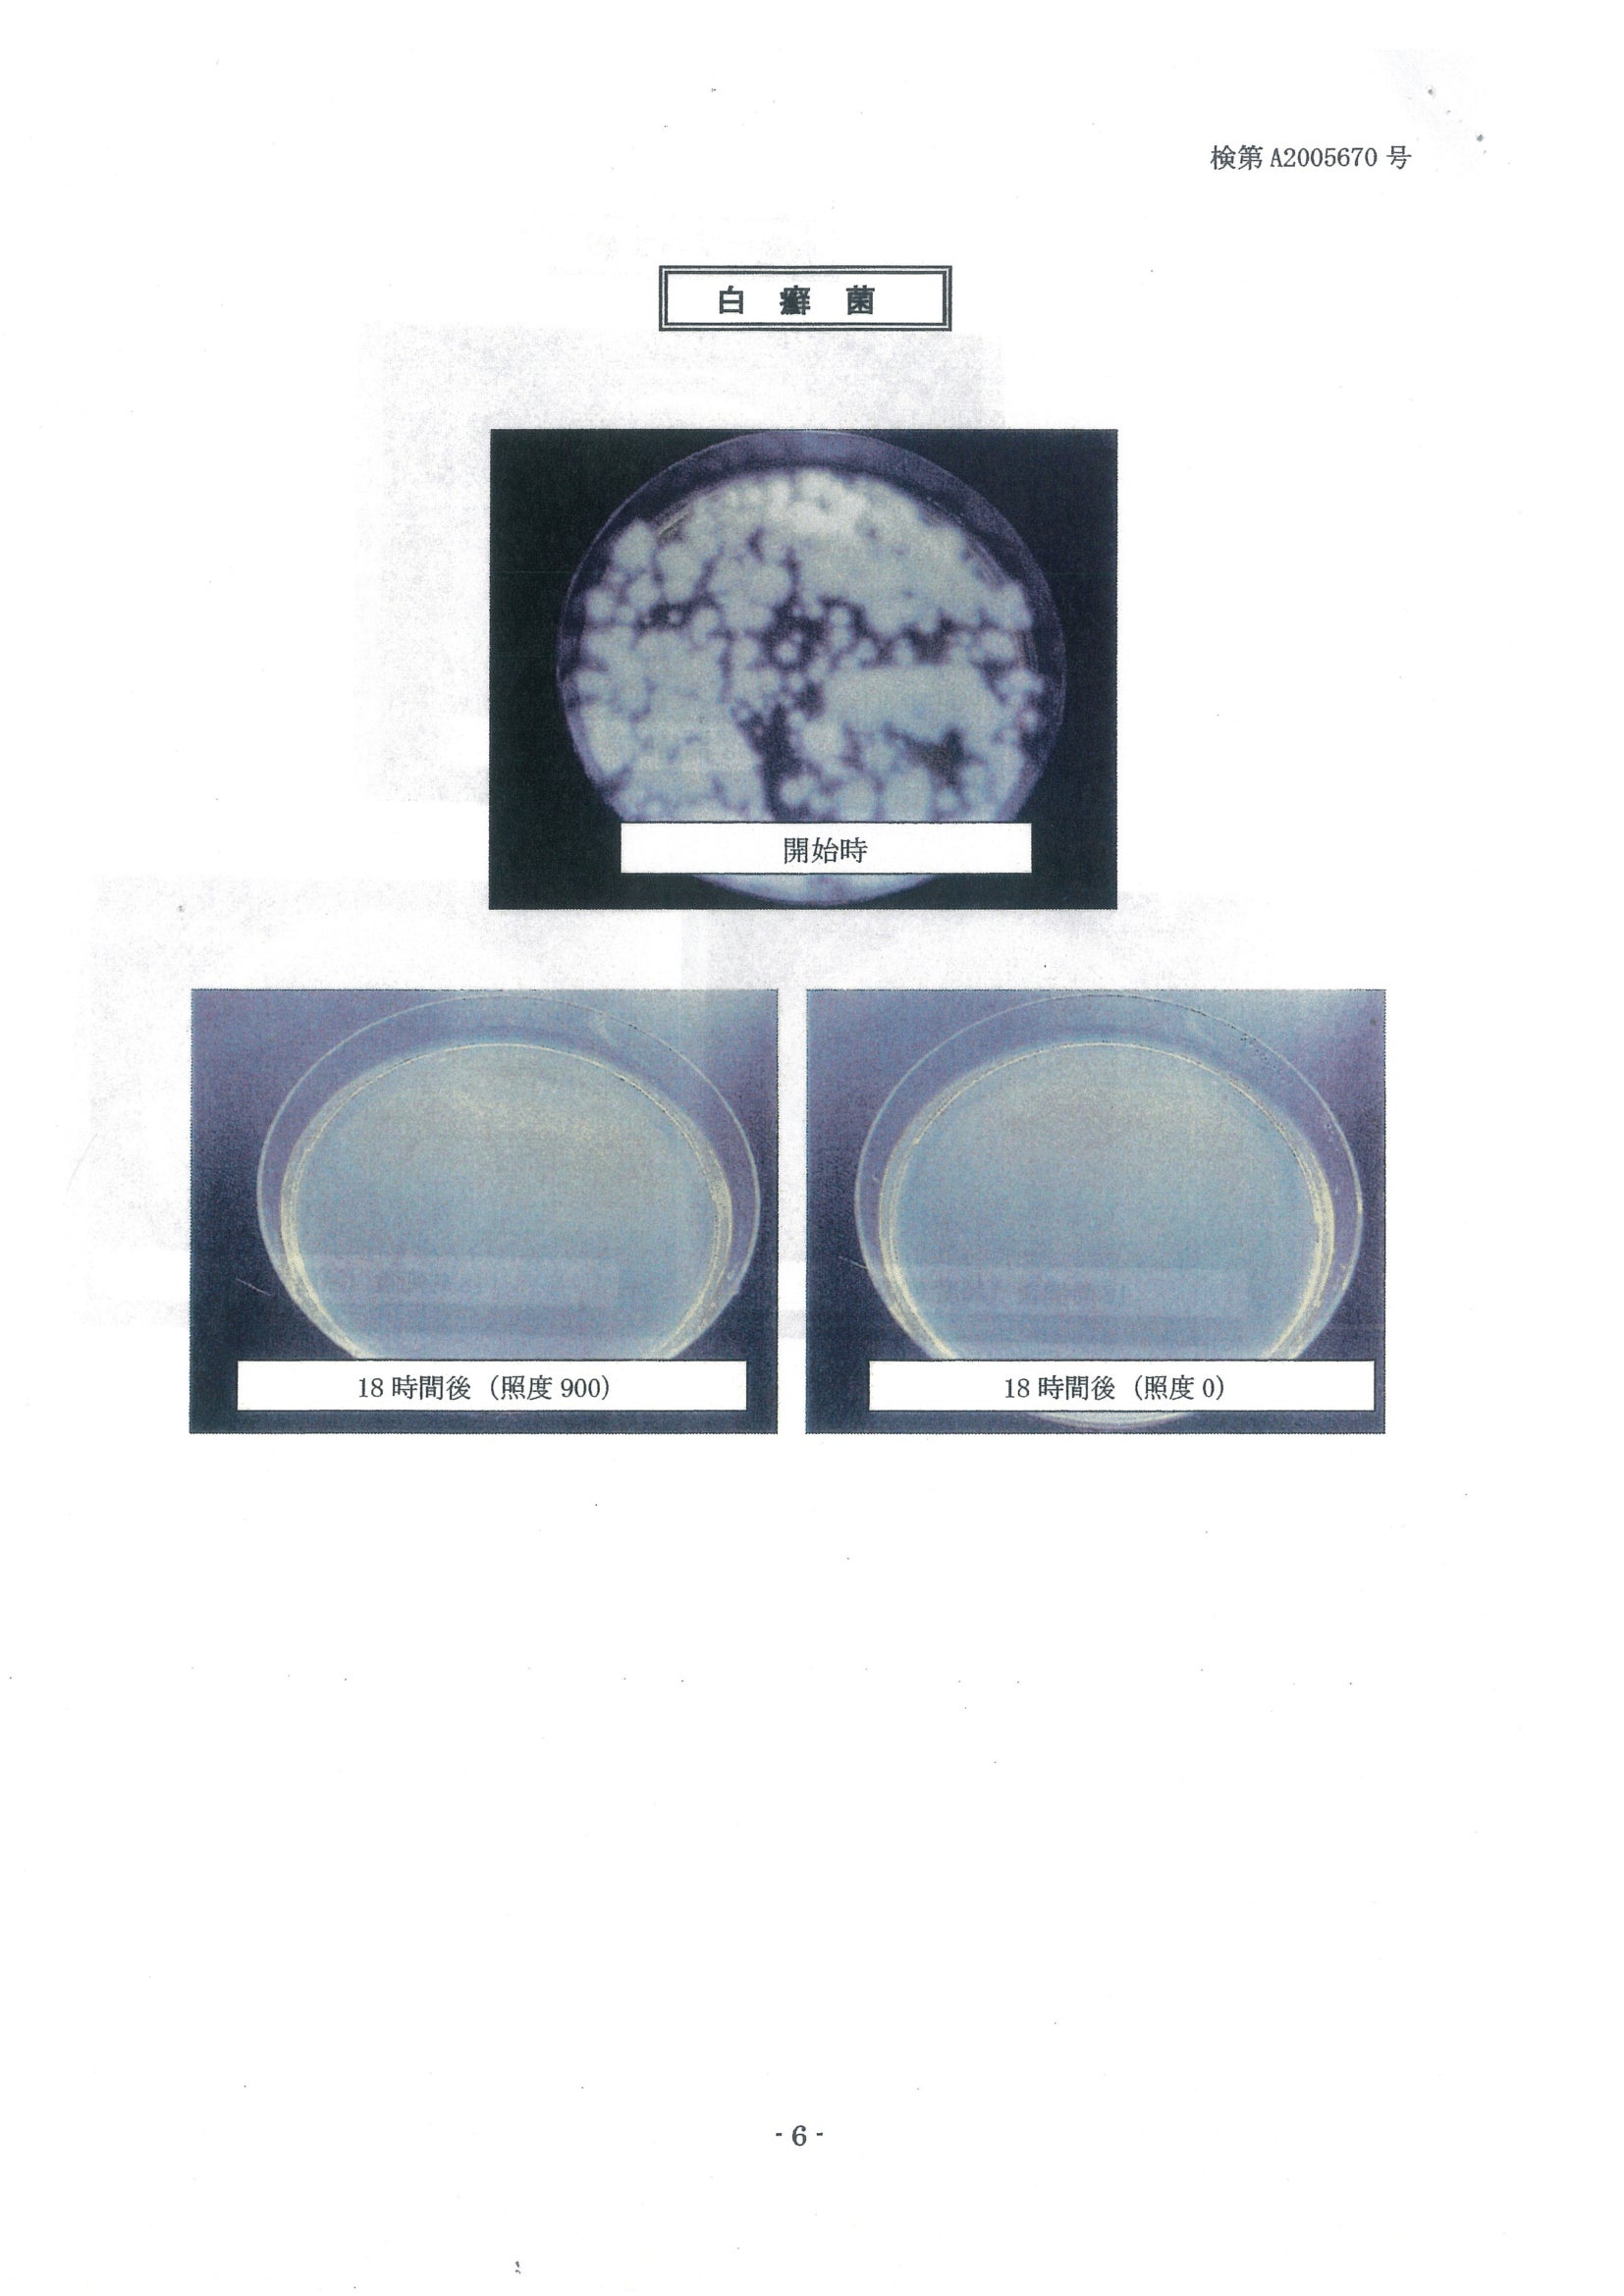

はじめに・ご挨拶
”殺菌と消臭のパイオニアであること”「株式会社遠赤エコセラ研究所」

皆様、こんにちは。遠赤外線と二酸化チタン種の革命的技術、「遠赤エコセラ」を提供する株式会社遠赤エコセラ研究所です。
私共の会社は 令和3年10月1日 島根県雲南市に産声を上げたばかりの『株式会社 遠赤エコセラ研究所』と申します。

※代表取締役会長:小林 知男
そもそも、なぜ会社を立ちあげたかと申し上げますと 有限会社ギムティー(食品加工販売)と言う会社で5年間に亘り遠赤外線と二酸化チタン種の研究を続けて参りました。

私は本年8月には、遠赤エコセラを活用した「エコセラ基盤」による光触媒の試験結果を得て多様な可能性に自信を持つことができ、この素晴らしい可能性を商品化することが出来れば人々の暮らしに貢献できるのではないかと考えたことにほかなりません。
そこから、遠赤エコセラの持つ脱臭性能や除菌性能に着目した空気清浄機の開発に心血を注ぎ、特許取得を得て製品を完成することができました。(特許第6923975号)
当社は 社是として”殺菌と消臭のパイオニアであること”を揚げ日々邁進して参ります。
エコセラ基材を使用した 種々な商品を開発し全社一丸となって 多くの利益を挙げ税金を払い “社会に貢献すること”を心に刻みながら事業に精励したいものと考えます。どうぞよろしくお願い致します。
遠赤エコセラとは

遠赤エコセラは、光触媒と中空セラミックビーズの特徴を併せ持つ、様々な用途へ応用が可能な素材です。
科学的に証明された遠赤エコセラの技術
私たちの技術は、5年の継続的な研究から生まれました。特に、エコセラ基盤による光触媒の強力な殺菌・消臭効果は、その高い効果が科学的に証明されています。
【ウイルスの不活化】
ウイルスに対し99.9%※1の不活化効果が認められています。
- ※1 (株)食環境衛生研究所 試験による試験結果(PDF)
実使用空間での実証結果ではありません。効果は使用状況によって異なります。あらゆるウイルスに効果を示すというものではありません。
【細菌の殺菌 】
大腸菌(食中毒など)・黄色ブドウ球菌(悪臭の元)・白癬菌(カビ)に対し18時間で99.9%
- ※2 (公財)島根県環境保健公社 試験による試験結果

【悪臭成分の分解】

悪臭の原因となるガス成分であるアンモニア・酢酸・ピリジンを1時間後には95〜97%※3、エチレンガスを3日間で99%※4減少させる効果が認められています。
- ※3 (公財)島根県環境保健公社 試験による試験結果(PDF)


- ※4 (公財)島根県環境保健公社 試験による試験結果(PDF)

-
【保温・断熱】
【中空セラミックビーズの効果】
体温を反射して保温し同時に外からの温度を遮断することで温かさを保ちます。 体温より外気の温度が高い場合には熱を遮断することで涼しさを感じられます。
このプロジェクトで実現したいこと
私たちは「遠赤エコセラ白足袋」を通じて、日常の快適さと健康を革命的に向上させることを目指しています。私たちの技術がもたらす殺菌・消臭効果と保温機能を組み合わせたこの足袋は、冷え性や不快な臭いに悩む多くの方々の解決策となると確信しております。
また、このプロジェクトを通じて、遠赤エコセラ技術の可能性を広く知っていただき、今後の研究開発のバックボーンとすることも大きな目的の一つです。さらなる商品開発や技術の進化を推進し、より多くの人々の生活の質を向上させるための第一歩を踏み出します。
プロジェクトをやろうと思った理由

縁結びの神・福の神として名高い 出雲大社の宮司様から伺いました。
冬季は風も強く寒さが非常に厳しく体や足が冷えて体に負担がかかるとのお話でした。
このお言葉からヒントを得まして考案致しましたのが我社の遠赤エコセラコート塗料を仕様し、製造した断熱シートからできた「エコセラ白足袋」です。
「困っている方々からの声で完成した商品です」
特許取得済みの遠赤エコセラ技術を用いて、新たな商品「エコセラ白足袋」を開発しました。この足袋は、細菌の殺菌や悪臭の除去、そして寒さを凌ぐための保温性能を持つ、まさに革命的な製品です。


自分の体温により足袋が温かくなり、また二酸化チタンの光触媒反応によりウイルスや細菌類が滅失、アンモニア臭も焼却します。
足袋の起源の一つには5世紀ごろ中国から伝わったとされる「シタウズ(襪)」という履き物が発展したという説があります。
今では神職・僧侶等の方々が服を着用される際に履き物として草履・下駄等足の親指と他の指が分かれたものを履きます。
それは2つに分かれていることにより足の力が地面に対して強く付くからに外なりません。
これは裸足と一般のシューズを履いた時と比べこの履物を履く際素足に履くものとして足袋があります(素足の保護)
足袋を履くのは季節を問いませんが特に冬季は寒さを凌ぐための必需品となります。
体験者(雲南市 神職)のコメント


神職として奉仕してから30年以上経ちますが、冬の足先の寒さは堪えるしかないと諦めていました。
この足袋を履いてみたところ、気温の低いところでもとても温かく、自分の体温を保ってくれるように感じます。
室内に入っても、自分の体温以上になることがないので、蒸れることもなく、とても快適です。
今まで使用してきたネル裏地の足袋が必要なくなりそうです。
-------
体験者(松江市 神職)コメント


冷え性の私は冬季の社務がつらく、特に足下(足袋)の対策には困っていました。
でもこの足袋なら、つま先まで長時間にわたってぽかぽか温かく、その上見た目も全く変わらないので、人の目も気になりません。
真冬の底冷えする神社での社務も快適になり、一気に問題解決となりました。
特徴
①臭いが取れる技術
「殺菌・消臭機能を備えた断熱シート及びその製造方法」


第690333号 令和3年6月25日登録済みです。
上記特許による殺菌と消臭機能を備えた断熱シートを使用した足袋です(二酸化チタンの光触媒による効果)

断熱シートとは我社が回は厚した特殊塗料を塗布した光触媒シート
②温かくなる理由がある
足袋底の断熱シートに体の熱が伝わると遠赤外線が発生します。
遠赤外線の波長は、人の身体、特に皮膚の分子の振動の周波数に合っている為、身体の表面に吸収されるのです。
だいたい200μの深さまでほとんど吸収されて熱に変わります。
この熱が体表面近くにある毛細血管を流れる血液などを通して身体の内部に効率よく伝わるので身体の表面だけでなく奥の方まで温まるのです。





これまでの活動
私たちの活動の起源は5年前に始まりました。それは有限会社ギムティーとして、食品加工販売の業界での遠赤外線と二酸化チタン種の研究でした。この研究が、現在の遠赤エコセラ技術へと発展していきました。
初期研究: 我々が遠赤エコセラを発見したのは、数々の試行錯誤を経てのことでした。最初の2年間は、基本的な研究として、遠赤外線と二酸化チタン種の相互作用を深く探求しました。
製品開発: 次の段階として、私たちは空気清浄機の開発に取り組みました。これは遠赤エコセラの脱臭性能や除菌性能を最大限に活用するためのものでした。
特許取得: 私たちの努力が実を結び、特許第6923975号を取得。これは私たちの技術と独自性を認められる大きな一歩でした。
商品化と市場へ: そして最近、私たちの技術を活用した「エコセラ基盤」の開発を成功させ、市場への導入を果たしました。
フィードバックの収集: その後、多くの方々からのフィードバックを受け取りながら、商品の改善と新しいアイディアの収集を続けてきました。特に、縁結びの神・福の神として名高い出雲大社の宮司様からの貴重な意見を元に、今回の「エコセラ白足袋」の開発に至りました。
これまでの活動を通じて、私たちは常に新しい技術とその可能性を追求し続けてきました。そして、今回のクラウドファンディングを通じて、さらなる飛躍を目指しています。
資金の使い道

・商品制作費用:150,000円
・商品PR費用:70,000円
・発送費:30,000円
リターンについて



足袋:男性 大人用
サイズ:22cm・23cm・24cm・25cm・26cm・27cm
色:白
こはぜ:4枚
超早割り¥2,500円
早割 ¥3,000円
通常 ¥4,500円
実施スケジュール

スタート:11月1日
終了:12月1日
リターン発送日:2023年12月5日
到着予定日:順次
最後に
私たちが追い求めるのは、単なる技術や商品の開発ではありません。それは、日々の暮らしの中での一瞬一瞬の快適さと、健康を真心で願う人々への深い思いやりです。遠赤エコセラ技術は、私たちの情熱の結晶、そして多くの方々の生活をより良くしたいという願いが詰まっています。
しかし、この革命的な技術と製品を、多くの人々に届けるためには、あなたの応援が不可欠です。一緒に、冷えや不快な臭いから解放された新しい生活を手に入れ、その喜びを多くの人々と分かち合いましょう。
「エコセラ白足袋」はただの製品ではありません。それは、私たちの心からの贈り物、そして未来への一歩です。私たちの情熱とビジョンを共有し、この革命に参加してください。
今、あなたの手には、私たちと共に新しい未来を切り開く鍵が握られています。心からの感謝とともに、あなたの熱い応援をお待ちしております。
<募集方式について>
本プロジェクトはAll-in方式で実施します。目標金額に満たない場合も、計画を実行し、リターンをお届けします。





コメント
もっと見る